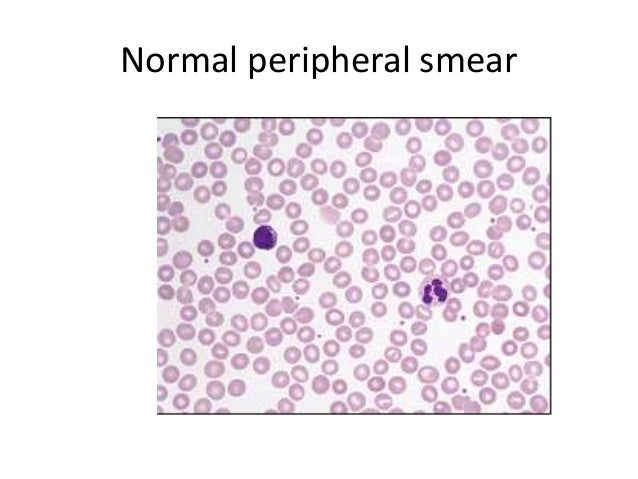

Feathered Edge Blood Smear Definition

How To Read A Blood Smear Pathology Student

Blood Smear Features Eclinpath

Icsh Recommendations For Identification Diagnostic Value And Quantitation Of Schistocytes Zini 12 International Journal Of Laboratory Hematology Wiley Online Library
Feathered Edge Blood Smear Definition のギャラリー
Q Tbn 3aand9gcqyfdj6r1z76pa Quyg1wpniuutctwuixbdcjuk5v0be6zwr Dy Usqp Cau

Ppt Blood Smear Examination Powerpoint Presentation Free Download Id

Blood Smear Preparation And Staining
Peripheral Blood Smear Examination

Blood Smear An Overview Sciencedirect Topics

1 General Assessment Veterian Key

Introduction To Peripheral Blood Smear Examination Oncohema Key

Peripheral Blood Smears Veterian Key
Q Tbn 3aand9gcrlx Inkl6jzzwcom3uyfk Iuoe3jva1yvnx5gkuqnnmmqphwk1 Usqp Cau
Cvm Ncsu Edu Wp Content Uploads 16 09 Blood Smear Basics 16 Pdf
Q Tbn 3aand9gcqeofm Xrgfbqs6ks9sbgdsmv Od6hg3rj2gs74zxd Uowal1ym Usqp Cau
Cvm Ncsu Edu Wp Content Uploads 16 09 Blood Smear Basics 16 Pdf

Pathophysiology Peripheral Blood Smears Flashcards Quizlet

Hematology Flashcards Quizlet

Part One Deferential White Blood Cells Count Diff Wbcs Count And Microscopic Examination Of Well Stained Blood Film Page 2 Medicine Science And More
Www Gundersenhealth Org App Files Public 6779 Lab Policies Differential Counting And Morphology Lab 5074 Pdf

Blood Smear A Nada Al Juaid Ppt Video Online Download
Apps Who Int Iris Bitstream 1637 1 Eng Pdf

Haematology Karen At James Cook University Studyblue

Peripheral Blood Smear Examination
Www Agric Wa Gov Au Sites Gateway Files Master your blood smear technique Pdf
Cvm Ncsu Edu Wp Content Uploads 16 09 Blood Smear Basics 16 Pdf

Making A Great Blood Smear Sonopath

Approach To Lymphocytosis Ask Hematologist Understand Hematology

How Do I Make A Good Blood Smear Vetgirl Veterinary Ce Podcasts

Pdf Purpose And Criteria For Blood Smear Scan Blood Smear Examination And Blood Smear Review
White Blood Cell Differential Wikipedia
Http Nabsnet Com Au Wp Content Uploads 18 08 Dafwa 14 Master Your Blood Smear Technique Pdf

Peripheral Smear

Thin Blood Vs Thick Blood What Is The Difference Induced Info
Q Tbn 3aand9gct6erwufqjkalgfec2 Ocyry5hcrfpfe0lcr9ii Ge Usqp Cau

Diagnostic Blood Smear Preparation Clinician S Brief
Cvm Ncsu Edu Wp Content Uploads 16 09 Blood Smear Basics 16 Pdf

Blood Film Wikipedia

The Feather Edge Of A Peripheral Blood Smear From The Initial Blood Download Scientific Diagram

Blood Smear A Nada Al Juaid Ppt Video Online Download

Clinical Case Challenge What Can You Learn From A Peripheral Blood Smear News Center At Cummings School Of Veterinary Medicine At Tufts University
Cvm Ncsu Edu Wp Content Uploads 16 09 Blood Smear Basics 16 Pdf

Ppt Blood Smear Examination Powerpoint Presentation Free Download Id

Peripheral Blood Smears Veterian Key

Samples For Hematology Cornell University College Of Veterinary Medicine

Practical Assessment Of Blood Smears In Dogs And Cats In Practice

Pdf Purpose And Criteria For Blood Smear Scan Blood Smear Examination And Blood Smear Review

Clinical Case Challenge What Can You Learn From A Peripheral Blood Smear News Center At Cummings School Of Veterinary Medicine At Tufts University

Making A Great Blood Smear Sonopath

In Clinic Hematology The Blood Film Review Today S Veterinary Practice

1 General Assessment Veterian Key

How Do I Make A Good Blood Smear Vetgirl Veterinary Ce Podcasts

In Clinic Hematology The Blood Film Review Today S Veterinary Practice
Cvm Ncsu Edu Wp Content Uploads 16 09 Blood Smear Basics 16 Pdf

Blood Smear Authorstream

Three Minute Peripheral Blood Film Evaluation Preparing The Film Dvm 360

Monolayer On A Blood Smear Eclinpath

Vett 117 Weeks 1 6 Exam 1 Study Guide Diagram Quizlet

How To Read A Blood Smear Pathology Student

Pdf Purpose And Criteria For Blood Smear Scan Blood Smear Examination And Blood Smear Review

Edge Blood Smear Definition And Function Sdn 1 Bancar

Blood Smear Preparation And Staining

Blood Film Wikipedia
Cvm Ncsu Edu Wp Content Uploads 16 09 Blood Smear Basics 16 Pdf

Icsh Recommendations For Identification Diagnostic Value And Quantitation Of Schistocytes Zini 12 International Journal Of Laboratory Hematology Wiley Online Library

Smear Examination Eclinpath

Feathered Edge Of A Blood Smear Eclinpath

Peripheral Blood Smears Veterian Key

1 General Assessment Veterian Key

Identifying Blood And Bone Marrow Abnormalities In The Laboratory Springerlink
Camlt Org Wp Content Uploads 17 09 Hematology Essentials A Foundation For Accurate Smear Reviews 3 17 Pdf

Blood Smear A Nada Al Juaid Ppt Video Online Download

Introduction To Peripheral Blood Smear Examination Oncohema Key
Http Site Iugaza Edu Ps Wlaithy Files Practical Hematology Pdf

Wbc Plt Estimates Inclusions

In Clinic Hematology The Blood Film Review Today S Veterinary Practice

Pathophysiology Peripheral Blood Smears Flashcards Quizlet

Ppt Preparing A Blood Smear Powerpoint Presentation Free Download Id

Blood Smear A Nada Al Juaid Ppt Video Online Download

Making A Great Blood Smear Sonopath

Diagnostic Blood Smear Preparation Clinician S Brief

Blood Smear An Overview Sciencedirect Topics

Diagnostic Blood Smear Preparation Clinician S Brief
Cvm Ncsu Edu Wp Content Uploads 16 09 Blood Smear Basics 16 Pdf

1 General Assessment Veterian Key

Peripheral Blood Smear Examination

Week 4 Practical Methods Introduction To Haematology Blood Smear Differential Cell Count Flashcards Quizlet

Ppt Preparing A Blood Smear Powerpoint Presentation Free Download Id

Peripheral Blood Smear Examination

Rbc Morphology On A Peripheral Smear

Feathered Edge Of Peripheral Blood Smear Medical Laboratories

Peripheral Blood Smear Examination

Some Bedside Laboratory Tricks Basicmedical Key
Cvm Ncsu Edu Wp Content Uploads 16 09 Blood Smear Basics 16 Pdf

Blood Film Wikipedia

In Clinic Hematology The Blood Film Review Today S Veterinary Practice

How Do I Make A Good Blood Smear Vetgirl Veterinary Ce Podcasts

Practical Assessment Of Blood Smears In Dogs And Cats In Practice

Feathered Edge Of Peripheral Blood Smear Medical Laboratories

Blood Smear Test Procedure Staining Interpretation Video Lesson Transcript Study Com
Cvm Ncsu Edu Wp Content Uploads 16 09 Blood Smear Basics 16 Pdf

Peripheral Blood Smear Examination

Automated Erythrocyte Detection And Classification From Whole Slide Images

Making A Great Blood Smear Sonopath

Practical Assessment Of Blood Smears In Dogs And Cats In Practice